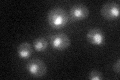
YER172C
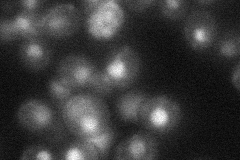
YER172C
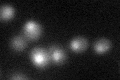
YER172C

View description
RNA-dependent ATPase RNA helicase (DEIH box); required for disruption of U4/U6 base-pairing in native snRNPs to activate the spliceosome for catalysis; homologous to human U5-200kD
Localization:
Intensity:
Fold change:
Significance:
-
C’ GFP library in SD
nucleus24.7 -
N' NOP1pr-GFP in SD

nucleus61.1059 -
N' TEF2pr-mCherry in SD

nucleus53.1791 -
N' NATIVEpr-GFP in SD
nucleus26.681 -
N' TEF2pr-VC and Cyto-VN in SD

nucleus38.185 -
C’ GFP library in SD+DTT
nucleus23.950.96No -
C’ GFP library in SD+H2O2

nucleus27.111.09No -
C’ GFP library in Starvation Media

nucleus21.550.87No -
C’ GFP library on the background of Pup2-DaMP

nucleus -
C’ GFP library on the background of CCT mutant

nucleusN/AN/ANo
